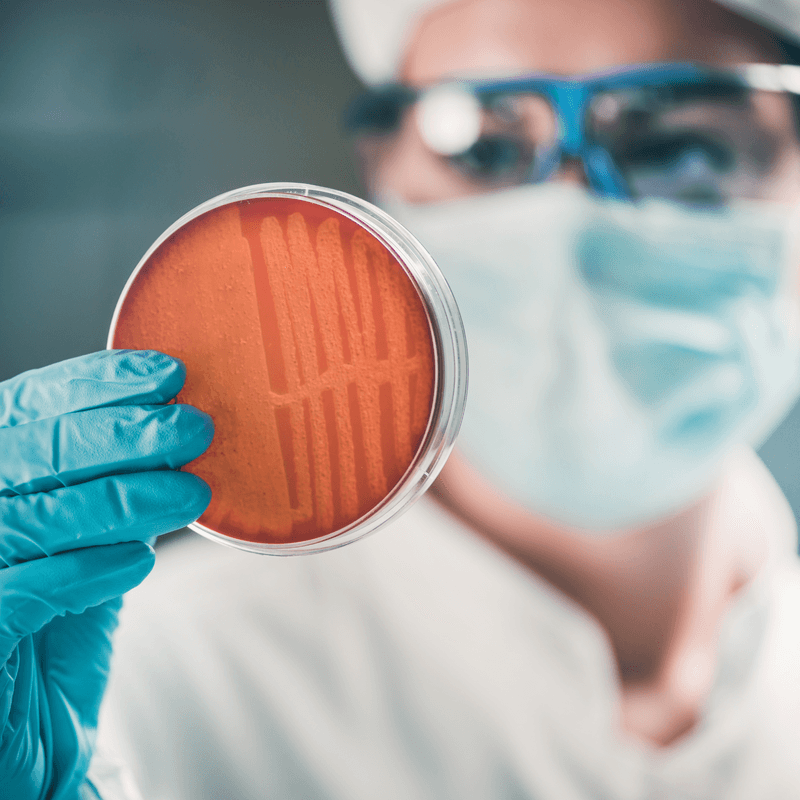

Scientific recruitment
If it’s scientific candidates you’re after, look no further. We work with pharmaceutical, chemical, biotechnology, and diagnostic companies to secure the talent needed to make new discoveries, push boundaries, and effect change. We’ll only ever put forward the strongest candidates for interview – those that most closely match your criteria – by determining qualifications, experience, person-spec suitability, and career goals. And our recruitment specialists are on hand to create a tailored recruitment strategy for you, so all that’s left is for you to do is get in touch to see how we can help.
Some of the roles we recruit for

Pharmacovigilance officers
Microbiologists

Chemists

Formulation chemists

DMPK scientists

Qualified persons

Instrumentation scientist

Laboratory managers

Material specialists

Analysts

Application scientists

Pharmacokinetic officers

Validation officers


